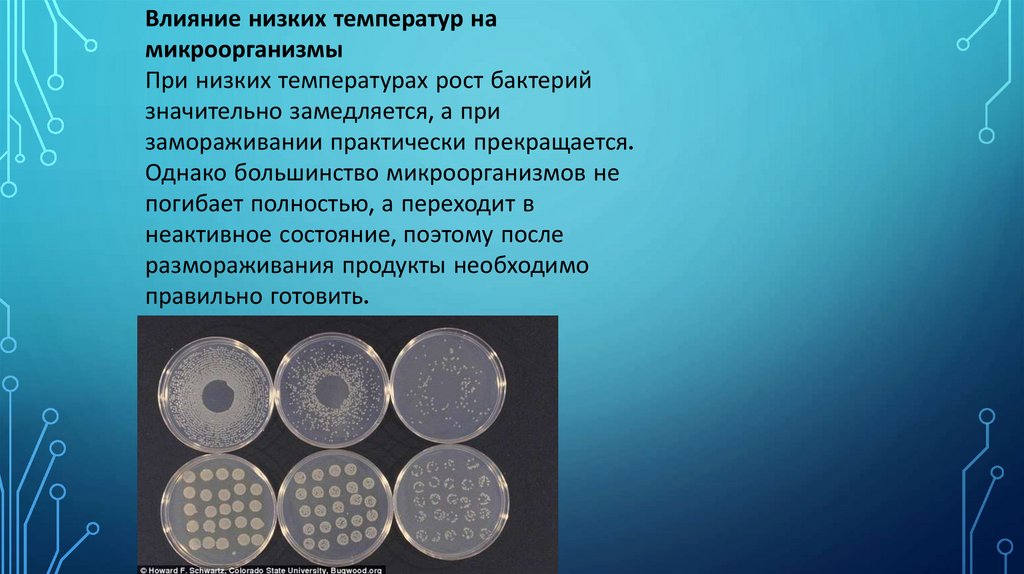

Похожие презентации:
2
1.
МИНИСТЕРСТВО ПРОСВЕЩЕНИЯ РЕСПУБЛИКИ КАЗАХСТАНКОЛЛЕДЖ МЕЖДУНАРОДНОГО ИНЖЕНЕРНО ТЕХНОЛОГИЧЕСКОГО УНИВЕРСИТЕТА
Тема:Холодильная обработка продуктов как способ
сохранения свежести.
Г.Алматы,2025
Выполнил:Кыстаубаев Алдияр Мадиярович
Группа:24:ТППП-3РО
Курс:2 Курс
Проверила:Қамысбаева Данагүл Ерналқызы
2.
Понятие холодильной обработкипродуктов
Холодильная обработка — это способ
хранения пищевых продуктов при
пониженных температурах, направленный
на замедление процессов порчи и
сохранение свежести. При охлаждении
снижается активность микроорганизмов и
замедляются химические реакции, что
позволяет дольше сохранять качество
продуктов без использования консервантов.
3.
Основные виды холодильной обработкиРазличают охлаждение, замораживание и
глубокую заморозку. Охлаждение
осуществляется при температуре от 0 до +4
°C и используется для кратковременного
хранения. Замораживание происходит при
температуре ниже −18 °C и позволяет
сохранять продукты в течение длительного
времени.
4.
Влияние низких температур намикроорганизмы
При низких температурах рост бактерий
значительно замедляется, а при
замораживании практически прекращается.
Однако большинство микроорганизмов не
погибает полностью, а переходит в
неактивное состояние, поэтому после
размораживания продукты необходимо
правильно готовить.
5.
Сохранение пищевой ценности продуктовХолодильная обработка позволяет
сохранить витамины, белки и минеральные
вещества в большей степени, чем тепловая
обработка. Особенно хорошо сохраняются
свежие овощи, фрукты, мясо и рыба. Однако
при неправильной заморозке возможна
потеря текстуры и вкуса.
6.
Влияние на внешний вид и качествоПри соблюдении температурного режима
продукты сохраняют цвет, форму и вкус.
Повторное замораживание может ухудшить
качество и привести к потере влаги.
Правильная упаковка помогает
предотвратить высыхание и поглощение
посторонних запахов.
7.
ВыводХолодильная обработка является
эффективным и доступным способом
сохранения свежести продуктов. Она
замедляет процессы порчи, сохраняет
питательные вещества и продлевает срок
хранения. Соблюдение правил охлаждения
и заморозки обеспечивает безопасность и
высокое качество пищи.

Кулинария
Кулинария








